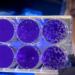
E.E.: 25 εκ. ευρώ για τη σύνδεση της έρευνας με την αγορά

Παράλληλα με το Συνέδριο EMD στη Ραβέννα (19-20 Μαΐου 2022), εκδηλώσεις EMD (European Maritime Day) In My Country 2022 θα πραγματοποιηθούν σε όλη την Ευρώπη από τον Απρίλιο έως τον Οκτώβριο του 2022.
Το EMD In My Country είναι ένα βασικό μέρος της πρωτοβουλίας ευαισθητοποίησης και ακτιβισμού για τους ωκεανούς που αυξάνεται σταθερά τα τελευταία χρόνια: οι εκδηλώσεις υπό την επωνυμία της γίνονται όλο και πιο δημοφιλείς, προσελκύοντας περισσότερους από 25.000 συμμετέχοντες κάθε χρόνο.
Οι τοπικές δραστηριότητες όπως καθαρισμοί παραλιών, ξεναγήσεις λιμανιών, εκθέσεις τέχνης, εργαστήρια, συνέδρια, σεμινάρια, εκθέσεις με ναυτιλιακά θέματα, δράσεις για τον αλφαβητισμό των ωκεανών, οικολογικές περιηγήσεις και περιπάτους σε περιοχές με σημαντική θαλάσσια κληρονομιά, εκδρομές με σκάφος, επισκέψεις σε ναυτικά μουσεία, τα πλοία, τα ενυδρεία, τα ναυπηγεία κ.λπ. απευθύνονται σε ένα ευρύ κοινό σε όλη την Ευρώπη, με ένα στοιχείο “διασκέδασης και παιχνιδιού” που απευθύνεται άμεσα σε ένα νεότερο κοινό.

#EMD In My Country
Το 2022 θα είναι το Ευρωπαϊκό Έτος Νεολαίας, επομένως ενθαρρύνονται πολλές εκδηλώσεις με επίκεντρο τις δραστηριότητες για τη νεολαία.
Όλοι οι διοργανωτές θα λάβουν βιώσιμα gadgets με την επωνυμία #EMD In My Country και οι εκδηλώσεις τους θα προωθηθούν μέσω των καναλιών ενημέρωσης της Γενικής Διεύθυνσης Θαλάσσιων Υποθέσεων και Αλιείας.
Καθώς η πανδημία του COVID-19 δεν έχει ακόμη τελειώσει, το EMD In My Country 2022 θα περιλαμβάνει φυσικές, εικονικές και υβριδικές εκδηλώσεις που θα πραγματοποιηθούν από την 1η Απριλίου έως τις 31 Οκτωβρίου 2022.
Είστε έτοιμοι να υποβάλετε τις εκδηλώσεις σας για το 2022; Κάντε αίτηση για τις δικές σας εκδηλώσεις για την Ευρωπαϊκή Ημέρα Ναυτιλίας στη Χώρα μου 2022, συμπληρώστε τη φόρμα αίτησης πριν από τις 15 Φεβρουαρίου 2022 και φέρτε την Ευρωπαϊκή Ημέρα Ναυτιλίας 2022 στη χώρα σας.
Το EMD In My Country 2021
Το EMD In My Country 2021 περιελάμβανε 232 εικονικές και, όπου είναι δυνατόν, φυσικές και υβριδικές εκδηλώσεις, που διοργανώθηκαν σε 25 χώρες (21 χώρες της ΕΕ και 4 χώρες εκτός ΕΕ), καλύπτοντας όλες τις θαλάσσιες λεκάνες της ΕΕ, κάνοντας απόλυτο ρεκόρ στην ιστορία της Ευρώπης Ημέρα Ναυτιλίας!

ΣΥΜΠΛΗΡΩΣΤΕ ΕΔΩ ΤΗ ΦΟΡΜΑ ΣΥΜΜΕΤΟΧΗΣ